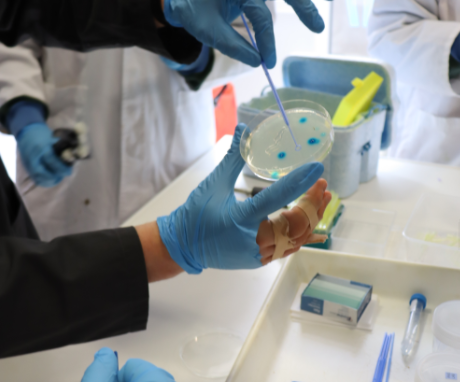
Biology swab.png

Want to know how the human body fights disease or how science is used to solve crimes? Curious about the science associated with scuba diving or passionate about how to sustainably manage marine environments?
Studying science at Clontarf Beach State High School gives students the opportunity to investigate these questions and many more. At Clontarf Beach State High School, students explore a range of engaging and relevant scientific concepts and in doing so develop their scientific knowledge, critical and creative thinking and communication skills.
Our curriculum area encompasses a wide range of science disciplines. In Years 7, 8, and 9 are introduced to Biology, Chemistry, Physics, Earth Science and Marine Science, allowing students to develop a foundation, explore their interests and gain an appreciation of the relevance of science in everyday life.
In Year 10, students have the option of 2 subjects Science in Action and Science in Focus.
- Science in Action is a practical subject focused on applying concepts from Biology, Chemistry, Marine Science, Physics, and Earth and Space Sciences to real-world contexts. Students develop problem-solving skills through hands-on investigations and projects, preparing them for senior Applied subjects such as Aquatic Practices and Science in Practice, and vocational pathways.
- Science in Focus develops students’ scientific understanding and inquiry skills across Biology, Chemistry, Marine Science, Physics, and Earth and Space Sciences. Through experiments, data analysis, excursions and workshops, students are prepared for senior General science subjects and university pathways, including Biology, Chemistry, Marine Science and Physics.
In Years 11 and 12, students have the opportunity to select from the following science pathways:
Biology
Chemistry
Marine Science
Physics
Aquatic Practices
Science in Practice
Our science program provides students with a range of learning experiences including practical activities and the use of information and communication technologies (ICTs). Our facilities, including our innovative Eco Centre with a functioning aquaponics system and well-equipped scientific laboratories, provide students with opportunities to explore their curiosity for science. Students enhance their learning through excursions, student-led experiments and field studies, developing skills that support success both at school and beyond, in science-related careers and a wide range of other industries.
In studying science at Clontarf Beach State High School, students are able to develop necessary scientific knowledge and skills to make informed decisions and contribute to key challenges the world faces both now and in the future.
If you would like further information regarding science at Clontarf Beach State High School, please don’t hesitate to contact our Science Head of Department, Rachel Barrett, on (07) 3480 4777 or
rbarr13@eq.edu.au.